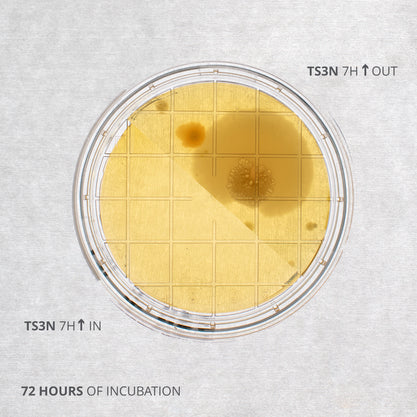
Air flow tests inside and outside a laminar flow hood using Triptic Soy agar plates
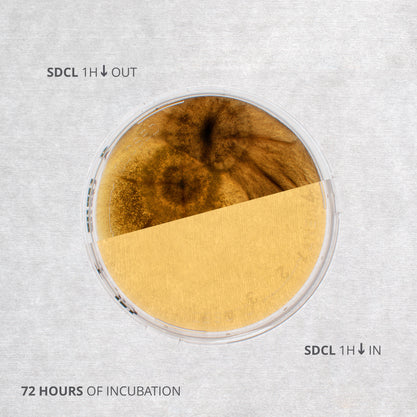
Contact tests inside and outside a laminar flow hood using Sabouraud Dextrose agar plates

Fully Equipped as Standard for Benchtop Experiments
With advanced sensor technology, set of filters, stainless steel tray, and UV lighting
Overview | Specifications | Features | Gallery | In the Box | Accessories | Resources and Support
Set up a clean air environment for working with sensitive samples in small-scale experiments. The Ossila Laminar Flow Hood is a simple-to-use, benchtop system designed to easily integrate uniform air flow into your lab capabilities.
Unlike many other laminar flow hoods, the system is fully equipped as standard with a HEPA filter, pre-filter, environmental sensors, control interface, UV light, and tray. Plus, the flat-pack design means you can assemble the hood according to your experimental needs:
- In the horizontal orientation, achieve clean laminar air flow with minimal turbulence for enhanced sample protection against external contamination.
- The vertical orientation can accommodate bulky equipment and reduces cross contamination between samples that are easily disturbed, like powders.
Uniform Air Flow
510 m3hour-1 with pressure sensors
Choose Your Setup
Assemble as vertical or horizontal
Particle Sensors
Continuous air quality management
UV Lighting
Guarantee a clean work surface
Key Specifications
Motor
| Motor Type | Single speed AC blower |
|---|---|
| Maximum Flow Rate | 510m3.hour-1 |
| Noise | 75 dB |
High Efficiency Particulate Air Filter
| Filter Grade | 99.99% (H13) particle filtration |
|---|---|
| Pore Size | 0.3 µm |
| Depth | 50 mm |
| ISO Classification | ISO Class 5 |
Particle Sensor
| Sensor Type | Light scattering discrete airborne particulate counter |
|---|---|
| Count Range | 0 particles.m-3 to 100,000 particles.m-3 |
| Count Accuracy | ±10% |
| Particle Size Bins | 0.3 µm – 1 µm, 1 µm – 2.5 µm, 2.5 µm – 5 µm, 5 µm – 10 µm |
Differential Pressure Sensor
| Sensor Type | MEMS barometric pressure sensor |
|---|---|
| Pressure Range | 30,000 Pa – 120,000 Pa |
| Accuracy | ±6 Pa |
| Resolution | ±0.2 Pa |
UV Light
| Type | High efficiency UV LED |
|---|---|
| Wavelength | 280 nm (UVC) |
| Intensity | 26 mW |
| Power Saving Feature | Automatic UV light off |
| Timer | 10, 15, 30 minutes, and indefinite |
Dimensions and Weight
| Vertical Orientation | Horizontal Orientation | |
|---|---|---|
| Work Surface | 590 mm x 630 mm (23.2" x 24.8") | 590 mm x 630 mm (23.2" x 24.8") |
| Internal Height | 570 mm (22.4") | 580 mm (22.8") |
| External Dimensions (W x H x D) | 660 mm x 908 mm x 660 mm (26" x 37.8" x 26") |
660 mm x 850 mm x 660 mm (26" x 33.5" x 26") |
| Weight | 24 kg | 24 kg |
Laminar Flow Hood Features

Fully Equipped and Flexible
Get set up straight away with a complete system which includes all the useful components as standard. Plus, the flatpack design means you don't need to decide on a configuration before purchasing. Assemble as a horizontal or vertical laminar flow hood depending on your experimental requirements (or switch between them, if needed).

High Purity Air
Guarantee a clean air workspace with a H13 grade HEPA filter which captures over 99.99% of all airborne particulates. High air purity as low as ISO Class 5 is easily achieved and maintained using the smart air sensing technology.

Smart Air Sensing Technology
Receive live updates about the environment and filter saturation from the advanced air quality and pressure sensors. The smart air sensing technology ensures the motor is operating at an optimal speed, alerts you to upcoming filter changes, and warns you if the air flow changes.

Low Operating Costs
Keep energy usage to a minimum and reduce your operating costs. The laminar flow hood is equipped with low energy lighting, infrared motion sensors for running in standby mode, a UV LED with variable timer settings, and back pressure sensing to monitor HEPA filter saturation.
Laminar Flow Hood Gallery
Horizontal Orientation

Vertical Orientation
Additional Specifications
Woven Microfiber Pre-Filter
| Filter Grade | 60% (F5) particle filtration |
|---|---|
| Depth | 10 mm |
White Light
| Type | High efficiency LED array |
|---|---|
| Brightness | 850 Lumens |
System
| Display Type | 24 bit color TFT LCD display |
|---|---|
| Display Resolution | 480 x 272 px |
| Display Size | 4.3" |
| Interface | Tactile keypad |
| Power Supply | IEC C13 power cable |
| Voltage Range | 220 V – 240 V |
| Fuse | 1 A |
Please note: Countries with 110V mains will require a step up transformer rated for powers up to at least 250W to operate the equipment.
Materials and Finish
| Plenum and Back Panels | 1.5 mm Aluminum, textured black powder coating |
|---|---|
| Clear Side Panels and Sash | 5 mm acrylic, transparent with polished edges |
| Working Surface Tray | 1.5 mm stainless steel, #4 brushed finish |
Certification and Standards
| UK Conformity Assessment (UKCA) |
Low Voltage Electrical Equipment Electromagnetic Compatibility Restriction of Hazardous Substances |
|---|---|
| Conformitè Europëenne (CE) Mark |
Low Voltage Directive (2014/35/EU) Electromagnetic Compatibility (EMC) (2014/30/EU) Restriction of Hazardous Substances (RoHS) (2011/65/EU + 2015/863) |
| International Standards | BS EN 61010-1:2010 Safety requirements for electrical equipment for measurement, control, and laboratory use. General requirements. |
In the Box
- Flat-pack laminar flow hood (configurable in vertical or horizontal setup)
- HEPA filter
- Pre-filter
- Stainless steel tray
Accessories and Related Products
Resources and Support
Getting Started with the Laminar Flow Hood
This short video guide shows you how to get started with your new equipment. It is easy to control the fan, lighting, and internal UV light.
Read more...